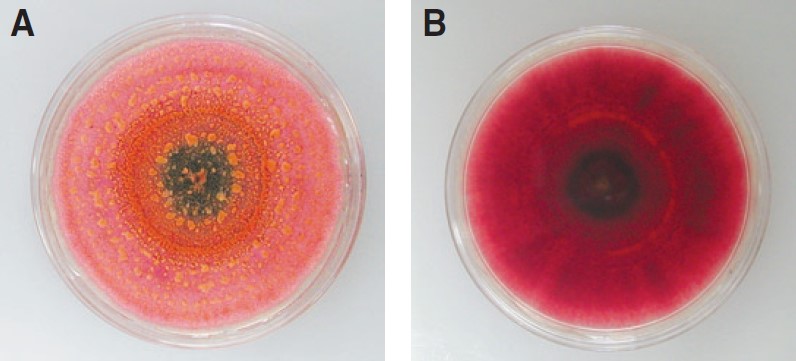

Bulletin E3039
Michigan Blueberry Facts: Anthracnose Fruit Rot (Ripe Rot)
DOWNLOAD
July 31, 2008 - Timothy Miles and Annemiek Schilder, Michigan State University Department of Plant, Soil, and Microbial Sciences
This Document is offered in: English, Espanol
Pathogen
Colletotrichum acutatum J.H. Simmonds Sexual stage: Glomerella acutata Guerber and Correll (Kingdom: fungi; class: ascomycetes)
Introduction
Anthracnose fruit rot is the most common and widespread fruit disease of blueberries in Michigan and the United States. This disease is typically caused by Colletotrichum acutatum. Colletotrichum gloeosporioides may also be found on blueberries in the southern United States. Anthracnose fruit rot can lead to substantial economic losses due to reduced yield, shelf life and quality of fruit. Preharvest fruit losses of 10 to 20 percent and postharvest losses of up to 100 percent have been reported. In addition, high levels of anthracnose fruit rot may contribute to unacceptable microbial counts in frozen processed fruit. Warm, wet seasons are particularly conducive to disease development.
Symptoms
Infected immature green berries are symptomless. Fruit rot symptoms usually do not become apparent until the fruit ripens; hence the name “ripe rot”. Initial symptoms are softening and shriveling of the fruit (Fig. 1), followed by the appearance of small orange dots (spore masses) on the fruit surface (Fig. 2). Fungal spores called conidia are produced in small blisters (acervuli), which break through the fruit skin (Figs. 3, 8C). The spore masses may look wet or dry, depending on the relative humidity and their age. Infected berries eventually shrivel up and fall off the bush. Even berries that look perfectly healthy at harvest can rot soon afterwards (Fig. 4), especially if not refrigerated. Colletotrichum acutatum may also cause blighting of blossoms and twigs, but these symptoms are difficult to distinguish from Phomopsis twig blight or Botrytis blossom blight without doing fungal isolations from the infected tissue. Cane cankers (Fig. 5A) and occasionally leaf spots have been observed during particularly rainy seasons.




Disease cycle
The fungus survives the winter in infected twigs, old fruit spurs and live buds. In spring and early summer, conidia are produced on these tissues (Fig. 5B-D) and dispersed by rain splash or overhead irrigation to blossoms and young developing fruit (Fig. 6). Sometimes blossom blight can occur and lead to twig blight. The fungus can infect fruit anytime between flowering and harvest.


The first step in the infection process is the germination of conidia (Fig. 8A) in the presence of water, followed by the production of melanized appressoria (infection cushions) (Fig. 8B) on the fruit surface. The fungus appears to require at least 8 hours of continuous wetness to initiate an infection at 77 F (25 C), which seems to be the optimum temperature for infection. However, infections can take place at lower temperatures if the fruit stays wet longer. Wetness periods of 24 hours or more result in severe infection. On unripe fruit, the infection remains latent until the fruit ripens. Then the fungus resumes its growth and colonizes fruit tissues, resulting in rotting and shriveling of the fruit. Within days, spore masses develop and eventually cover most of the berry (Fig. 4). The time from infection of ripe fruit to the first appearance of symptoms is about 7 days. Secondary infections occur through berry-to-berry contact or when spores are splashed from infected to healthy berries in the bush. Fungal spores may also be spread on harvesting and sorting equipment. On potato dextrose agar, Colletotrichum acutatum produces pink, fuzzy mycelium (dark red when viewed from below) (Fig. 7), although some strains may produce gray mycelium. As cultures age, they develop orange spore masses that contain ellipsoidal conidia measuring 8 to 16 (20) x 2.5-5 µm. The sexual stage of this fungus, Glomerella acutata, has been observed only in culture and has not been found in nature.

Management
Anthracnose fruit rot symptoms usually do not become apparent until close to harvest. Therefore, preventive control strategies are important, especially in fields with a history of the disease. An important disease management option is to plant resistant or less susceptible cultivars (Table 1). In addition, growers can create an environment that is less conducive to fungal growth and infection. Use drip irrigation or adjust timing of overhead irrigation to minimize wetness duration. Wide plant spacing and regular pruning will create an open canopy to promote air flow and rapid drying as well as fungicide spray penetration. Selectively pruning out dead wood can reduce overwintering inoculum, but the high cost associated with pruning may make it uneconomical. Anthracnose is more common on overripe fruit, so harvest promptly and frequently, and process fruit as quickly as possible after harvest. If harvested fruit cannot be transported right away, it should be stored in the shade. Postharvest spread of the disease can be reduced by harvesting and processing good fruit before bad fruit and by sanitizing equipment between harvests as needed. Rapid cooling of fruit is critical; ideally, cooling to 35 F (2 C) should occur within 2 hours after harvest. Preventive fungicides are most effective when applied from pink bud to harvest, in particular between bloom and pea-size green fruit and when the berries start to turn blue. Sprays between harvests may also be needed to reduce secondary infections. The efficacy of fungicides against anthracnose fruit rot varies (Table 2). Dormant sprays — e.g., lime sulfur — may aid in control by eradicating overwintering inoculum. For more information, see the Michigan Fruit Management Guide (MSU Extension bulletin E-154) or www.blueberries.msu.edu.
| Table 1. Susceptibility of highbush blueberry cultivars to anthracnose fruit rot. Rating is based on field observations as well as the proportion of fruit decay after artificial inoculation: 0-15% = resistant, 16-30% = moderately resistant, 31-50% = moderately susceptible, and 51-100% = susceptible (Polashock et al., 2005, Plant Disease 89:33-38). | |||
|---|---|---|---|
| Susceptible | Moderately susceptible | Moderately resistant | Resistant |
|
Bluecrop |
Berkeley |
Aurora |
Elliott |
* Duke, Murphy and Croatan show field resistance even though they were susceptible or moderately susceptible in the inoculation tests.
|
Table 2. Fungicide efficacy against anthracnose fruit rot (based on observations in field trials). | ||
|---|---|---|
| Fungicides | Active ingredient | Efficacy |
| Abound | azoxystrobin | Excellent |
| Aliette | fosetyl-Al | Good |
| Bravo* | chlorothalonil | Good |
| Cabrio | pyraclostrobin | Excellent |
| Captan | captan | Good |
| Captevate | fenhexamid + captan | Good |
| Elevate | fenhexamid | None |
| Indar | fenbuconazole | None |
| Lime sulfur | calcium polysulfide | Fair |
| Pristine | pyraclostrobin + boscalid | Excellent |
| ProPhyt | potassium phosphite | Fair |
| Rovral | iprodione | None |
| Serenade | Bacillus subtilis | Fair |
| Sulforix | calcium polysulfide | Fair |
| Switch | cyprodinil + fludioxonil | Good/Excellent |
| Ziram | ziram | Fair/Good |
*Bravo should not be applied after full bloom because of the risk of phytotoxicity.
We thank Bill Cline, James Polashock, Dave Trinka, James Hancock, and Lynnae Jess for their critical review of this fact sheet.



 Print
Print Email
Email

